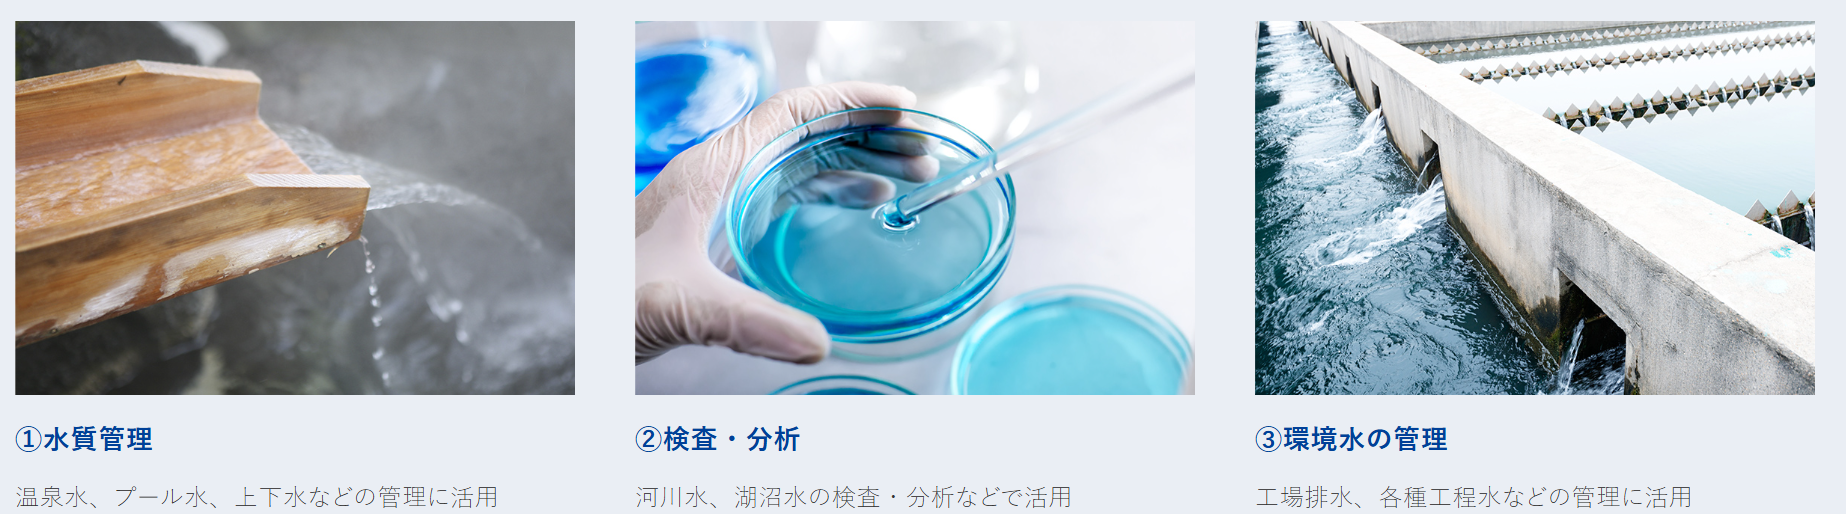
448e3640-2a81-467c-8b3a-f05b3e504d60.png 448e3640-2a81-467c-8b3a-f05b3e504d60.png

产品说明:
独特的650°C低温密封燃烧系统,拥有全天24小时持续测量污染水质的良好记录,
是一套实验室用TOC计,具备高可靠性和稳定性,适用于多种样品。

| 型式 | TOC-250L |
| 測定対象 | 水中の有機汚濁物質 |
| 測定項目 | TC NPOC(塩酸酸性曝気IC除去法)、オプション:IC TOC(TC-IC) |
| 測定方式 | 全炭素量測定:自動間欠式密封燃焼-赤外分析法 |
| 無機炭素除去:自動間欠式塩酸酸性曝気法 | |
| 無機炭素測定:自動間欠式塩酸酸性曝気-赤外分析法 | |
| 測定範囲 | TC、NPOC:0-2~2,000 mgC/L(希釈にて40,000mgC/Lまで測定可能) |
| IC:0-2~2,000mgC/L(希釈にて40,000mgC/Lまで測定可能) | |
| 測定周期 | 約4分30秒~ (前処理や共洗い洗浄時間を除く) |
| 再現性 | 変動係数1.5%以内または±0.05mgC/L以内でいずれか大きい方 |
| 直線性 | ±2%FS以内または±0.05mgC/L以内でいずれか大きい方 |
| 最小検出限界 | 0.05mgC/L未満(高感度仕様:0.02mgC/L未満) |
| 試料注入量 | 20~300μL可変 |
| 試料希釈 | 希釈倍率:2~20倍 希釈精度:±3%以内 |
| 表示 | カラー液晶タッチパネル デジタル表示(mg/L 小数点以下3桁表示) |
| 通信出力 | PC制御機能(オプション) USBによる測定データ最大9,000件をCSV形式で保存 |
| RS-232C RS-485(オプション) | |
| プリンタ | サーマルプリンタ[RS-232C](オプション) |
| 感度校正 | 全炭素(TC):フタル酸水素カリウム水溶液による手動校正 |
| 無機体炭素(IC):炭酸ナトリウム(無水)+炭酸水素ナトリウム水溶液による手動校正 | |
| キャリアガス | 0.3MPa 窒素(99.9%以上)または計装圧空 消費量:約10Nm3/月(IC曝気条件により変化) |
| (計装圧空はCO2除去フィルタが必要で水分/油分を含まないこと) | |
| 電源 | AC100V±10V 450VA 消費電力:約400W |
| 設置条件 | 屋内 周囲温度:5~40℃ |
| 外形寸法/質量 | 420±5(W)×532±5(H)mm(突起物を除く)×522±5(D) 約45kg |